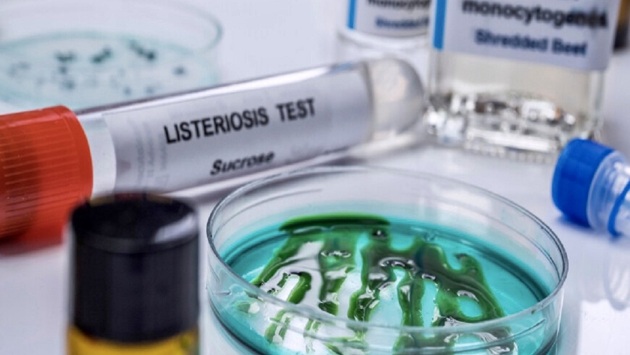

Инфекционист Степанова рассказала, чем опасно мясо, зараженное листерией
Ранее стало известно, что в партии курятины из Казахстана обнаружили листериоз. По словам врача-инфекциониста Екатерины Степановой, заражение этой бактерией мясной или молочной продукции может произойти на различных этапах производства. При этом определить наличие листерий можно только в лабораторных условиях.
В разговоре с 360.ru Степанова рассказала, что произойдет с человеком, если он съест зараженное мясо. У больного будут наблюдаться лихорадка, диарея, спутанность сознания и головная боль.
«Листериоз может приводить к менингиту, энцефалиту и другим тяжелым болезням. При беременности листериоз опасен для плода», — резюмировала врач.
Ранее врачи рассказали, как электронная сигарета вредит человеку. Врач предупредил, что на фоне использования электронных сигарет и вейпов развивается болезнь EVALI.